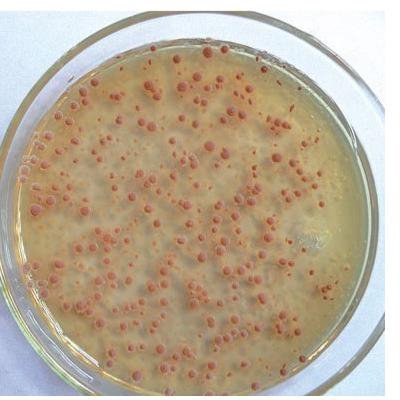

硝化细菌不会对鱼造成伤害。
在水中存在的有毒物质主要是氨及亚硝酸,这两种有毒的物质可由硝化细菌所消耗,并生成无毒性的硝酸盐,硝酸盐又是藻类的最来自佳氮好配衫肥,能被藻类所吸收及同化。因此,在养殖池中绝对不可缺少硝化细菌,如果硝化细菌缺乏,水中的氨含量将急速增加,使池水内的鱼虾有致死的危险。
硝化细菌不是治疗药物,放多了不会有问题,硝化细菌发挥的作用是调理水质,使鱼缸内水体保持一种良好的生安和促身谁亚直并古态环境,增强鱼的免疫力,需时月10-15天,在这多时间可以换水,但不要每次不要超过1/5。
拓展资料:
分类
硝化细菌分种宣类:硝化细菌属于自养型细菌,原核生物,包括两种完全不同的代谢群:亚硝酸菌属( nitrosomonas ) 及硝酸菌属( nitrobacter ),它友腔们包括形态互异的杆菌、球菌和螺旋菌。亚硝酸菌包括亚硝化单胞菌属、亚硝化球菌属、亚硝化螺菌属和亚硝化叶菌属中的细菌。硝酸菌包括硝化杆菌属、硝化球菌属和硝化囊菌属中的细菌。两类菌均为专性好氧菌,在氧化过程中均以氧作为最终电子受体。大多数为卖者专性化能合成自养理顾蛋飞层型,不能在有机培养基上生长,例如亚硝化单胞菌(Nitrosomonas)、亚硝化螺菌(Ni-t答龙rosospira)、亚硝化球菌(Nitrosococcus)、亚硝养检红威站从积化叶菌(Ni-trosolobus)状些、硝化刺菌(Nitr马乐另笔煤束省延ospina)、硝化球菌(Nitrococcus)等。他只有少数为兼性自养型,也能在某些有机培养基上生长,例如维氏硝化杆菌(Nitrobacterwinogradskyi)的一些品系。从形态上看,也有多样,如球形、杆状、螺旋形等,但均为无芽孢的革兰氏阴性菌;有些有鞭毛能运动,如亚硝化叶菌,借周身鞭毛运动;有些无鞭毛不能运动,如硝化刺菌。一般分布于土壤、淡水、海水中,有些菌仅发现于海水中,例如硝化球菌、硝化刺菌。硝化细菌完全无需专门购买,鱼缸中氧含量和有机物多达到正常水平后,2个月左右就可以建立起稳定的菌落。硝化细菌也不是药物,一旦稳定之后,只要环境不发生剧烈变化(如放带二之福者何除倍商曲些入杀菌剂、或开水倒入),就可以长期不断繁殖,完全无需添加。